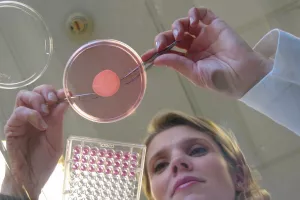
L&rsquo;Oréal predstavio svoju zelenu viziju ljepote u budućnosti

L'Oréal Adria pokreće beauty4thefuture – kampanju o važnosti razvrstavanja potrošenih pakiranja kozmetičkih proizvoda

Vanya Panayotova
L'Oréal Adria je, u suradnji s tvrtkom Hamburger Recycling Croatia, pokrenuo internetsku stranicu beauty4thefuture.hr kojom nastoji podići svijest potrošača o važnosti razvrstavanja potrošenih pakiranja kozmetičkih proizvoda. Cilj pokretanja ove stranice je kvalitetna edukacija potrošača o mogućnostima razvrstavanja i recikliranja higijenskih i kozmetičkih proizvoda, kao i poticanje njihovih odgovornih navika i ponašanja.
Mogu li se staklenke s kremom za njegu lica baciti u kontejner za staklo? Što napraviti s praznim bočicama šampona? Recikliraju li se ruževi i maskare? Ovo su samo neka od pitanja koja potrošači mogu pronaći na spomenutoj internetskoj stranici, a navike koje potrošači usvoje doprinijet će razvoju kružnog gospodarstva, smanjenju zagađenja okoliša, smanjenju količine plastičnog otpada i potaknuti društveno odgovorno ponašanje.
- Kao vodeća beauty kompanija u svijetu, cilj nam je pozitivno utjecati na društvo unutar kojeg poslujemo. Stoga ovom beauty4thefuture kampanjom i pokretanjem informativne internetske stranice nastojimo educirati potrošače o pravilnom načinu razvrstavanju kozmetičkog otpada, ali i pomoći im u donošenju održivih odluka prilikom kupnje kozmetičkih proizvoda - istaknula je Vanya Panayotova, generalna direktorica L'Oreala Adria.
Uključivanje potrošača u lanac odgovornosti
Kako bi ponovna upotreba materijala bila uspješna, ključno je da se u lanac odgovornosti uključe i potrošači. A upravo je razvrstavanje pakiranja kozmetičkih proizvoda izazov iz dvaju razloga, a to su raznolikost materijala i nedostatak informacija specifičnih za ovu kategoriju. Stoga mnoga pakiranja kozmetičkih proizvoda završe u kućnom (miješanom komunalnom) otpadu, umjesto u odlagalištima za recikliranje.
Kako bi se potrošači pravilno informirali o razvrstavanju ove vrste otpada, u kampanju beauty4thefuture uključit će se većina brendova L'Oréal grupe, omiljeni potrošačima u Hrvatskoj. Brendovi će putem svoje komunikacije prenositi poruku o reciklabilnosti pojedinog proizvoda uz upućivanje na edukativnu internetsku stranicu beauty4thefuture.hr koja objašnjava kako razvrstati različita pakiranja proizvoda prema materijalima od kojih su izrađena.
Sinergija vodeće beauty kompanije i Hamburger Recycling Croatia
Kao partner beauty4thefuture.hr inicijative, tvrtka Hamburger Recycling Croatia je pružila svoja iskustva i stručnost u pogledu selektivnog odvajanja otpada te ponudila platformu posvećenu razvrstavanju higijenskih proizvoda na svojoj internetskoj stranici hamburger-recycling.com. Organizacija je član Prinzhorn grupe i djeluje u 16 zemalja te je predvodnik na europskom tržištu po pitanju industrije pakiranja, papira i recikliranja.
S obzirom na to da pakiranja predstavljaju veliki dio globalnog otiska različitih proizvoda, L'Oréal grupa je već 2007. godine implementirala održivu strategiju pakiranja koja se temelji na tri načela (3R) - poštovanje (respect) sigurnosti kupaca, zdravlja i bioraznolikosti; smanjenje (reduce) težine i veličine pakiranja ili potpuno uklanjanje pakiranja te poticanje sustava za ponovno punjenje ili zamjena pojedinačnih doza višekratnim dozama te zamjena (replace) nekih materijala njihovim boljim inačicama.
Svojim novim globalnim program održivog razvoja L'Oréal for the future, kompanija se obvezala do 2030. godine smanjiti količinu pakiranja svojih proizvoda za 20 posto, kao i osigurati da sva plastična pakiranja njihovih proizvoda budu napravljena od recikliranih materijala ili materijala iz bioloških izvora. Grupa je također postavila cilj da do 2025. godine 100 posto plastičnih pakiranja bude pogodno za ponovno punjenje, recikliranje ili kompostiranje, doprinoseći tako razvoju kružnog gospodarstva.
{embed_digitalno_izdanje}{/embed_digitalno_izdanje}









